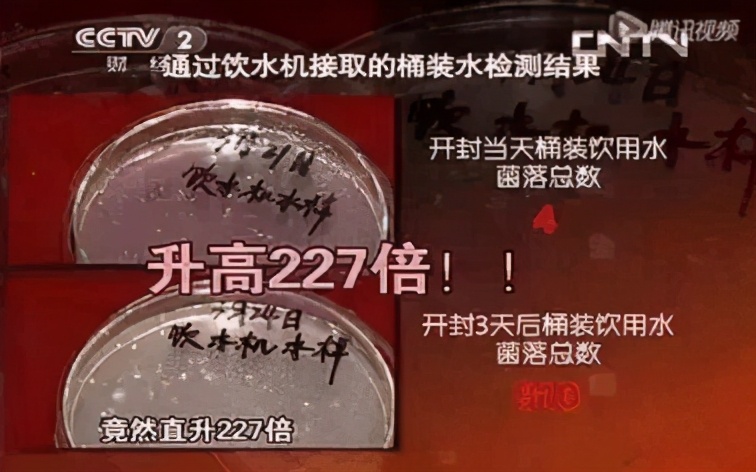
桶装矿泉水水质怎么样,桶装矿泉水水质好坏

摘要:从桶装水到进口高端矿泉水,频发的水质量问题令人堪忧,新鲜矿泉水成人们健康饮水新追求。
饮水机、桶装水,最早诞生于二十世纪七十年代的英国,兴起于二十世纪八十年代,曾因便捷饮水、标榜提升人们饮水质量和生活品位,在很长一段时间成为备受国人喜爱的饮水方式。然而,随着桶装水的不断发展,吸引了大量企业涌入桶装水行业,饮水健康问题频发。

桶装水行业乱象丛生,引发行业信用危机
据统计,2018年我国桶装水年销量已经超过7000万吨,使用桶装水曾是非常普遍的饮水方式。但随着行业发展,桶装水行业乱象丛生,一些桶装水企业的质量安全问题被频频爆光。

据央视315报道,桶装水出现恶劣的“黑心水”、“黑心桶”现象。“黑心水”,指的是有的桶装水企业,生产基地位于水源污染区,有的水源地甚至位于恶臭熏天的厕所旁,而不良商家直接抽取地下水灌装进桶装水桶里对外售卖;除“黑心水”外,采用“黑心桶”现象在桶装水行业里也已是公开的“秘密”。而所谓“黑心桶”就是用工业废料里的高分子聚合物制成的桶,这种聚合物会在水体环境中渗出,人们长期食用、接触,有极大的致癌风险。

另外,与桶装水配套搭载的饮水机,其内胆也是人们日常饮用水的细菌滋生大本营。人们在更换桶装水时,经常容易忽视内胆中一直存有近1000毫升的水,根据国家环境检测部门出具的报告显示,饮水机内胆超过3个月不清洗,就会滋生大量细菌,危害人体健康。
对此,有行业专家指出,由于桶装水行业近几年发展速度快,行业准入门槛低,一些不正规的小企业缺乏技术和品控人员,产品质量把控不稳定,造成了持续不断的桶装水质量问题。同时,在饮用阶段,消费者缺乏科学的饮用习惯,经常一桶水喝半个月甚至更久,也没有定期进行饮水机的清洗,长此以往也会对身体健康造成影响。
进口矿泉水也存在健康饮水隐患,新鲜矿泉水成健康饮水新需求
随着人们生活质量的提高,人们对饮水的认识也在不断深化。从“安全水”到“健康水”,人们对饮水品质的要求有了质的飞跃。曾经以便捷、安全为主要优势的国内桶装水,因为一些杂牌企业的进入,产品质量参差不齐,已经难以满足现代用户“饮水健康”的升级需求,很多家庭将目光转向了国外进口高端矿泉水,一时间像依云等国外诸多进口矿泉水品牌销量在中国市场迎来了迅猛增长。

一些国外进口高端矿泉水,标榜取水源自阿尔卑斯山的天然水源,历经15年的冰川砂层过滤,形成了天然弱碱性水,同时水里富含有利于人体健康的矿物质等等众多优势,被称为矿泉水界的“爱马仕”,高端水质曾一度让人们风靡。
然而,很多人不知道,天然矿泉水内含矿物质元素,特别不适合暴晒和长时间高温运输,否则水质会发生变化,“健康水”有可能变成“隐患水”。可目前进口矿泉水从海外运输至我国境内,再配送至各物流点,等送到用户家中,这期间距离灌装日期,可能已经过去三个月,遇到突发情况,时间就会更长。经历了几个月运输暴晒的进口瓶装矿泉水,可能已经中途变质。曾有用户反映某大牌进口瓶装矿泉水,开瓶后水质变得浑浊且饮用口感欠佳。至此,进口矿泉水的神话被现实打破,进口矿泉水的销量也将遭遇天花板。
可以发现,人们现在越来越追求健康的生活方式,吃新鲜的东西、喝新鲜的饮品。如今我们从鲜炖燕窝、掌握关键保鲜技术的坚果、鲜榨果汁等一众以“新鲜”概念为主打的品牌持续走俏市场现象中可以看出,各行各业的健康消费需求已向着新鲜化趋势迈进。
在水行业也不例外,如今“新鲜”在饮水需求上已初露端倪。当下桶装水问题频发、进口瓶装矿泉水也存在长期高温运输储存变质隐患,水作为每天维持生理健康的必需品,到底喝什么样的水才更安全健康呢?北京水质专家赵飞虹如是说:“喝白开水是安全的,但喝优质矿泉水更健康。”矿泉水中含有丰富的适合人体健康的矿物质和微量元素,如果饮用新鲜的矿泉水,将是未来更加有利于健康的正确、科学的饮水方式。
如此看来,在人类健康饮水需求大趋势下,新鲜矿泉水或将成为水行业发展的下一个新风口!